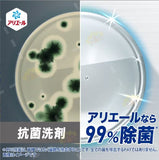

Roll over or click image to zoom in
P&G Ariel Ultra Concentrated Triple Action Disinfectant Clothing Wash Gold 700g
2
sold in last
8
hours
BEAUTY & HOMEWARES
$13.99
DESCRIPTION
- Triple 99 % sterilisation targets clothes, wash water and drum at once—total protection for the family.
- Instantly zaps stubborn odours without soaking, saving time and effort for fresh, clean laundry.
- Exclusive 18-hour antibacterial shield keeps bacteria at bay so garments stay fresh for longer.
- 10 % ultra-concentrated—same dosage washes five more pieces, good for your wallet and the planet.
- Works on all fabrics and machines; one-rinse cycle cuts water and power billsnn From: https://babymall.hk/en/product/pg-ariel-ultra-concentrated-triple-action-disinfectant-laundry-liquid-gold-700ml/
HOW TO USE
- About 45 mL of detergent per 45 L of water in a general-type washing machine
- Can be used by refilling all bold liquid bottles.
- It is more effective if you apply it directly to stubborn stains, leave it for a while (about 5 minutes), and then wash it in the washing machine.
- Before washing, please check the care instructions on the clothing.
- This is not a drink.
customers are viewing this product
The minimum spend for an order is AUD $0 (inclusive of GST). Shipping only available in Australia.
DELIVERY OPTIONS
Pickup available at Merry Seasons City Store (Usually ready in 24 hours)
Standard Delivery
Flat rate $12 will be applied for all orders with standard delivery in Australia (WA excluded). Flat rate $15 will be applied for all orders in West Australia. FREE on orders $149 or over (WA excluded). National delivery within 3-7 business days. Delivery times via Australia Post or TNT to Western Australia, and regional and remote locations in Northern Territory, South Australia, Queensland and Tasmania may still be a little longer than usual.